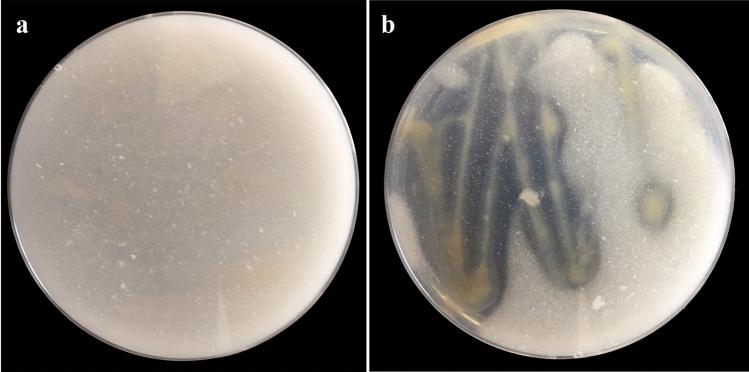

具有固氮能力的盐沼固氮菌 YRNF3:一种可能的碳酸钙溶解生物剂,可改善石灰性土壤性质。
Diazotrophic Azotobacter salinestris YRNF3: a probable calcite-solubilizing bio-agent for improving the calcareous soil properties.
机构信息
Plant Protection and Biomolecular Diagnosis Department, Arid Lands Cultivation Research Institute (ALCRI), City of Scientific Research and Technological Applications (SRTA-City), New Borg El-Arab, 21934, Egypt.
Land and Water Technologies Department, Arid Lands Cultivation Research Institute (ALCRI), City of Scientific Research and Technological Applications (SRTA-City), New Borg El-Arab, 21934, Egypt.
出版信息
Sci Rep. 2023 Nov 23;13(1):20621. doi: 10.1038/s41598-023-47924-w.
Calcareous soils are characterized by a high calcium carbonate content (calcite), which plays a crucial role in the soil structure, plant growth, and nutrient availability. The high content of CaCO leads to the increment of the soil alkalinity, which results in a lowering of the nutrient availability causing a challenge for the agriculture in these soils. In this study, the calcite-solubilizing potential of the diazotrophic Azotobacter salinestris YRNF3 was investigated in vitro as a probable bio-agent for enhancing the calcareous soils properties such as soil pH and nutrient availability. Twelve diazotrophic bacterial strains were isolated from wheat rhizosphere collected from different wheat-cultivated fields in five Egyptian governorates. Using Nessler's reagent, all isolated bacterial strains were found to have the ability to produce ammonia. By amplification of nifH gene, a PCR product of 450 bp was obtained for all isolated bacterial strains. For each isolate, three biological and three technical replicates were applied. All isolated diazotrophic bacteria were qualitatively screened for their calcite-solubilizing ability. To quantitatively investigate the calcite-solubilizing potential of A. salinestris YRNF3 in vitro, changes in the contents of soluble calcium (Ca), bicarbonate (HCO), total nitrogen (TN), total protein (TP), and pH were daily measured in its culture filtrate along 10 days of incubation. The results showed that the pH values in the culture filtrate ranged from 5.73 to 7.32. Concentration of Ca and HCO in the culture filtrate significantly decreased with the increment in the incubation time, while concentration of TN increased along the time. The highest TN concentration (0.0807 gL) was observed on days 4 and 5, compared to that of the day 0 (0.0014 gL). Content of TP in the culture filtrate also significantly increased along the incubation period. The highest TP content was recorded in day 4 (0.0505%), while no TP content was recorded on day 0. Furthermore, data obtained revealed that A. salinestris YRNF3 produced acid phosphatase at low activity (5.4 U mL). HPLC analysis of the culture filtrate indicated production of different organic acids, namely lactic acid (82.57 mg mL), formic acid (46.8 mg mL), while acetic acid was detected in a low quantity (3.11 mg mL). For each analysis, three replicates of each treatment were analyzed. Means of the tested treatments were compared using Tukey's HSD test at p ≤ 0.05. In conclusion, findings of this work suggested that A. salinestris YRNF3 has the potential to be a probable bioagent to be used for the reclamation of the calcareous soils by solubilizing CaCO, improving soil fertility, and promoting plant growth. However, further studies are needed to investigate its field application and their long-term effects on the soil properties and plant productivity. To the best of the author's knowledge, this is the first study reporting the calcite-solubilizing ability of a nitrogen-fixing bacteria. Having these two abilities by one microorganism is a unique feature, which qualifies it as a promising bioagent for reclamation of the calcareous soils.
钙质土壤的特点是碳酸钙(方解石)含量高,这在土壤结构、植物生长和养分供应中起着关键作用。高含量的 CaCO 导致土壤碱度增加,从而降低了养分的有效性,这对这些土壤中的农业生产构成了挑战。在这项研究中,研究了固氮菌 Azotobacter salinestris YRNF3 的方解石溶解潜力,作为一种可能的生物制剂,用于增强钙质土壤的特性,如土壤 pH 值和养分供应。从五个埃及省不同小麦种植田的小麦根际中分离出 12 株固氮细菌菌株。使用 Nessler 试剂,发现所有分离的细菌菌株都具有产生氨的能力。通过 nifH 基因的扩增,获得了所有分离的细菌菌株的 450 bp 的 PCR 产物。对于每个分离株,都应用了三个生物学和三个技术重复。定性筛选所有分离的固氮细菌的方解石溶解能力。为了定量研究 A. salinestris YRNF3 在体外的方解石溶解潜力,在 10 天的孵育过程中,每天测量其培养液中可溶性钙(Ca)、碳酸氢盐(HCO)、总氮(TN)、总蛋白(TP)和 pH 的变化。结果表明,培养液的 pH 值范围为 5.73 至 7.32。随着孵育时间的增加,培养液中 Ca 和 HCO 的浓度显著降低,而 TN 浓度则增加。在第 4 和第 5 天观察到最高的 TN 浓度(0.0807 gL),而第 0 天的 TN 浓度(0.0014 gL)较低。培养液中 TP 的含量也随着孵育时间的延长而显著增加。在第 4 天记录到最高的 TP 含量(0.0505%),而第 0 天没有记录到 TP 含量。此外,获得的数据表明,A. salinestris YRNF3 产生低活性的酸性磷酸酶(5.4 U mL)。培养液的 HPLC 分析表明产生了不同的有机酸,即乳酸(82.57 mg mL)、甲酸(46.8 mg mL),而乙酸的含量较低(3.11 mg mL)。对于每种分析,每个处理的三个重复都进行了分析。使用 Tukey 的 HSD 检验比较测试处理的平均值,p 值≤0.05。总之,这项工作的结果表明,A. salinestris YRNF3 具有通过溶解 CaCO 来改良钙质土壤、提高土壤肥力和促进植物生长的潜在能力,可用作可能的生物制剂。然而,需要进一步的研究来调查其田间应用及其对土壤特性和植物生产力的长期影响。据作者所知,这是首次报道固氮细菌具有方解石溶解能力的研究。一种微生物同时具有这两种能力是一个独特的特征,使其成为改良钙质土壤的有前途的生物制剂。